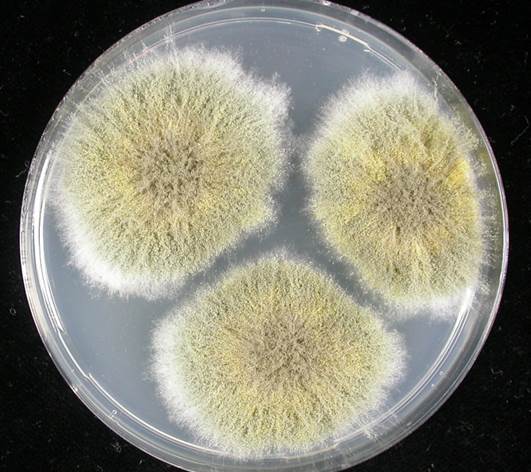
Eurotium repens.jpg

드럼세탁기와 좁쌀곰팡이
곰팡이 이야기 4
세계최대 전자회사 중의 하나인 별셋전자의 세탁기와 지난주에 이야기한 오징어채에 피었던 좁쌀곰팡이와 관련된 이야기 하나 소개합니다. 이 이야기에는 저자의 자랑질이 포함되어 있으니 미리 대비하고 읽어 주시기를 바랍니다.
꽤나 오래전 가을! 느닷없이 별셋전자의 종합연구팀(?)에서 나를 찾아왔다. 곰팡이 때문에 제품 수출에 문제가 생겼는데 시급히 해결해야 한다고.
“미국에 드럼세탁기 오백대(정확지 않다)를 배로 보냈습니다. 미국 항구에 도착해 통관 절차를 밟는데 포장 박스를 뜯었더니 세탁기를 고정하고 있던 나무판(Particle board)에 정체불명의 곰팡이가 피어 있었습니다. 이에 미국 관세청은 통관을 허락하지 않고 무슨 곰팡인지, 문제는 없는지를 해결한 후에 통관시켜 주겠다고 합니다. 해서 드럼세탁기는 하역하지도 못하고 배에 묶여 있습니다. 계약상 수일 안에 세탁기를 납품해야 하는데 그렇지 않으면 위약금을 물어야 합니다. 어떻게든 빨리 해결해 주시면 충분히 사례하겠습니다.”
매우 중요하고 시급한 일로 판단되었다. 그렇다고 해서 나도 동조해서 서두를 수도 없고 원칙적인 답변을 늘어났다.
“곰팡이 이름을 밝히는 것을 동정이라고 하는데 곰팡이 동정에는 통상 2주일이 걸립니다. 많이 걸리면 한달이 될 수 도 있고 경우에 따라서는 동정이 어려울 수도 있습니다. 일단 해당 샘플을 봐야 답변을 드릴 수가 있습니다.”
별셋전자 직원이 가지고 온 나무판을 건넸고 거기에는 육안으로 보기에도 선명하게 곰팡이가 피어 있었다. 무슨 곰팡이일까 나도 자못 궁금했다.

<파티클 보드 일반카메라 사진>
합판을 해부현미경 재물대에 올려놓고 보는데 푸른색 곰팡이들이 합판위에 나무들처럼 무성하게 자라 있었다. 이게 뭘까? 광학현미경으로 더 확대해서 봐야지 하던 중, 헐! 푸른나무 숲들 사이로 좁쌀이 보이지 않는가! 가장자리에는 좁쌀곰팡이가 많이 피어 있었다.

< 파티클보드의 해부현미경 확대 사진 25배>
 <
<<피티클보드의 해부현미경 확대 사진 50배>
이건 좁살곰팡이(Eurotium)이가 맞다. 유사 곰팡이도 있겠지만 직관적으로 좁쌀곰팡이임을 알 수 있었다. 형태가 일치할 뿐만이 아니라 환경 조건 등도 좁쌀곰팡이와 맞다.
곰팡이들 옆에 이름모를 애벌레가 죽어 있었는데 아마도 어떤 연유에선가 벌레가 났고 이들의 분비물 때문에 물기가 생겼으며 물기가 있자 공기중에 돌아다니던 포자가 발아하여 자리를 잡았을 것이다. 배로 옮겨졌으면 꽤 긴 기간 동안 환기가 없는 상황에서 습기가 있고 나무라는 먹이가 있으니 곰팡이가 자랄 수가 있다. 특히 낮은 습도에서도 자랄수 있는 좁쌀곰팡이가 발생할 수 있다.
“해결할 수 있을 것 같습니다. 시간도 많이는 걸리지 않을 것 같아요. 일단 공문으로 동정의뢰 처리해 주시고요, 결과는 진행되는 대로 말씀드리겠습니다.
“경비는 얼마나 들까요? 말씀주시면 얼마든지 처리토록 하겠습니다.”
“막걸리 한잔이면 됩니다.”
ㅎㅎㅎ, 속으로 웃음이 나왔다. 얼마나 멋진 말이냐! 기백만원은 마음먹고 왔을 텐데 막걸리 한잔이면 된다니......,
결국 이 곰팡이는 형태적으로 먼저 답이 나왔고 유전자 검정을 통하여 Eurotium herbariorum (현재명 Aspergillus glaucus)과 E. repens (현재명 A. pseudoglaucus)가 함께 있는 것으로 동정되었다. 이 곰팡이는 미국을 포함한 전 세계에 흔히 있는 곰팡이고 인체, 동물, 식물에 아무런 문제가 되지 않으므로 그 부분을 브러시로 불어내고 닦아 내면 그만이었다. 이에 별셋전자에서는 아무런 경제적 손해 없이 해당 세탁기를 수출할 수 있었다.

<그림 4, 파티클보드의 주요 곰팡이 Eurotium repens, DG18 배양 사진>
이 건은 세탁기 수출과 관련된 것이지만 실상 좁쌀곰팡이(Eurotium, 현재는 Aspergillus section Aspergillus)는 육포와 같은 건어물, 그리고 잼과 같은 졸인 음식을 오염시켜서 흔히 문제가 된다. 그런데 식품 공장에서 이를 배지에 키워 보면 자라질 않는다. 식품에서는 육안으로 명백히 보이는데, 분리는 않되고 무슨 곰팡인지도 모르고 속앓이를 하는 경우가 많았다.
답은 의외로 간단하다. 분리 배지를 바꿔주면 된다. 우리나라에서는 곰팡이 배양하면 우선 PDA(감자한천배지, Potato Dextros Agar)를 쓴다. 이는 영양분이 풍부하고 수분이 많은 배지로 대부분의 곰팡이들이 잘 자란다. 그런데 좁쌀곰팡이는 물기가 적은 낮은 수분활성도에서 잘 자라고 오히려 수분이 많으면 자라지를 못한다. 이 곰팡이를 수분이 많은 PDA에 올려 놓으니 주범 곰팡이는 자라지 않고 다른 잡균들만 자라 분리에 어려움이 있었다. 쉽게 이야기 하면 밭에 잘 자라는 놈을 논에다 심어 놓고 자라기를 바란 셈이다.
이 곰팡이를 분리 배양하려면 배지를 이 곰팡이가 잘 자라는 조건으로 만들어 주면 된다. 제일 쉬운 것은 쓰던 배지에 설탕(sucrose)을 20% 넣어 주면 된다(경우에 따라서는 50%까지 추가한다). 그러면 예들이 잘 자라는 정도의 수분활성을 갖게 된다. 이것이 번거로우면 호건성(Xerophilic) 곰팡이들을 키울 수 있는 전문배지인 DG18 (Dichloran Glycerol) Agar을 사용하면 된다.
<그림 5, DG8 배지(메디아뱅크 퍼옴-저자와 관련 없는 회사임)>
DG18 배지가 나왔으니 한 가지만 더. 국제식품균학위원회(ICFM, International Commission on Food Mycology, https://www.foodmycology.org/)에서 곡류, 채소, 과일 등 다양한 식품에 존재하는 곰팡이를 확인하고 싶을 때에 쓰는 표준 배지를 추천한 적이 있다. DRBC(Dichloran Rose-Bengal Chloramphenicol)와 DG18 인데, 수분활성도가 0,9 이상일 때는 DRBC를 0.9이하일 때는 DG18을 추천하였다(Modern Method in Food Mycology, 1992). 하지만 정확한 수분활성도를 모르니 그냥 두 개의 배지를 동시에 쓰면 된다. 물론 이 두 배지가 식품에 있는 곰팡이를 모두 분리할 수는 없지만 비교적 다양한 곰팡이를 손쉽게 분리할 수 있다. 이야기가 딴 곳으로 빠졌지만 이야기 나온 김에 식품 QC 하시는 분들이 알아 두면 도움이 될 것 같다.
마무리해야지. 별셋전자에서 일을 다 해결한 다음에 감사의 뜻을 표하고자 하였다. 공직자가 뭘! 근무시간에 국가의 녹을 먹고 주어진 일을 했을 뿐인데. 인계동의 막걸리 집에서, 상호가 ‘오 자네 왔는가?’로 기억한다. 별셋전자의 부장님인가 간부가 나와서 사줬는데 딱 막걸리 한잔만 1차로 먹고 헤어졌다. 아니 한잔은 아니고 두세병은 마셨겠지. 허세를 좀 떨어 가며 기분 좋게!